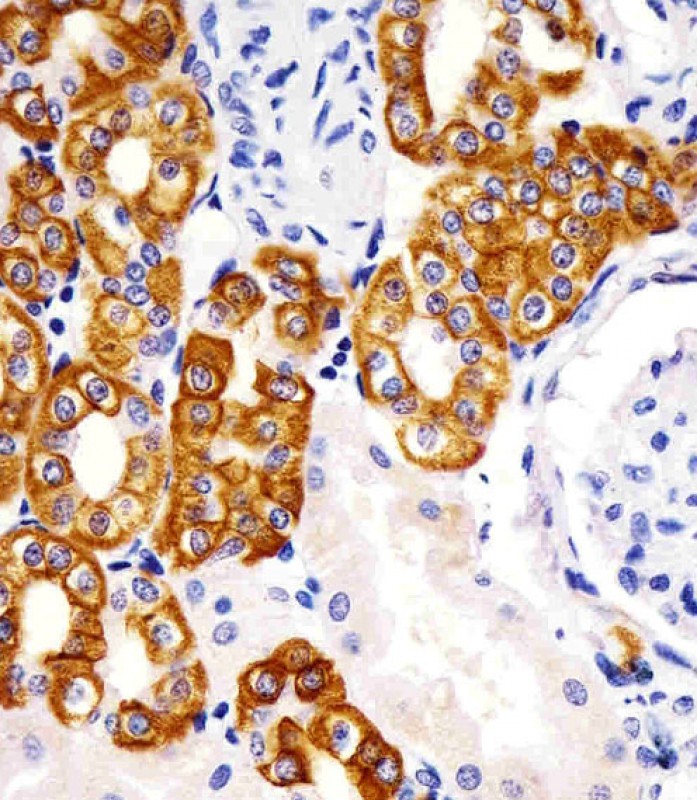

> Antigen, Antibodies, ELISA, Western Blot > Primary Antibody > Monoclonal Antibodies > KRT19 AntibodyBrand |
Leading Biology | Catalog Number |
APR17097G |
Product Type |
Monoclonal Antibodies | Field of Research |
|
Product Overview |
We constantly strive to ensure we provide our customers with the best antibodies. As a result of this work we offer this antibody in purified format.
We are in the process of updating our datasheets. If you have any questions regarding this update, please feel free to contact our technical support team.
This product is a high quality KRT19 antibody.
|
||
Molecular Weight |
44106 Da
|
||
Host |
Mouse
|
||
Species Reactivity |
Human
|
||
Target |
This antibody is generated from a mouse immunized with a recombinant protein of human.
|
||
Clone |
979CT14.3.1
|
||
Isotype |
IgG1,k
|
||
GeneID |
|||
UniProt ID |
|||
Function |
Involved in the organization of myofibers. Together with KRT8, helps to link the contractile apparatus to dystrophin at the costameres of striated muscle.
|
||
Summary |
Involved in the organization of myofibers. Together with KRT8, helps to link the contractile apparatus to dystrophin at the costameres of striated muscle.
|
||
Form |
Purified monoclonal antibody supplied in PBS with 0.09% (W/V) sodium azide. This antibody is purified through a protein G column, followed by dialysis against PBS. |
||
Storage & Stability |
Store at +4°C short term. For long-term storage, aliquot and store at -20°C or below. Stable for 12 months at -20°C. Avoid repeated freeze-thaw cycles.
|
||
Applications |
IF, IHC-P, WB, E
|
||
Dilution |
IF~~1:25
IHC-P~~1:25
WB~~1:4000
|
||
Synonyms |
Keratin, type I cytoskeletal 19, Cytokeratin-19, CK-19, Keratin-19, K19, KRT19
|
||
Images |

Immunofluorescent analysis of 4% paraformaldehyde-fixed, 0. 1% Triton X-100 permeabilized HepG2 (human liver hepatocellular carcinoma cell line) cells labeling Pdx1 with APR17097G at 1/25 dilution, followed by Dylight? 488-conjugated goat anti-mouse IgG (NA166821) secondary antibody at 1/200 dilution (green). Immunofluorescence image showing intermediate filaments staining on HepG2 cell line. The nuclear counter stain is DAPI (blue).
APR17097G staining KRT19 in human kidney sections by Immunohistochemistry (IHC-P - paraformaldehyde-fixed, paraffin-embedded sections). Tissue was fixed with formaldehyde and blocked with 3% BSA for 0. 5 hour at room temperature; antigen retrieval was by heat mediation with a citrate buffer (pH6). Samples were incubated with primary antibody (1/25) for 1 hours at 37°C. A undiluted biotinylated goat polyvalent antibody was used as the secondary antibody. 
All lanes : Anti-KRT19 Antibody at 1:4000 dilution Lane 1: MCF-7 whole cell lysates Lane 2: HepG2 whole cell lysates Lysates/proteins at 20 μg per lane. Secondary Goat Anti-mouse IgG, (H+L), Peroxidase conjugated at 1/10000 dilution. Predicted band size : 44 kDa Blocking/Dilution buffer: 5% NFDM/TBST. |
||
Specification |
|||
Quantity |
|
||
| Select | Brand | Catalog No. | Product Name | Pack Size | Type | Field of Research | Specification | Quantity | Price(USD) | |
| 1 | Leading Biology | APG02467G | CCK4 / PTK7 Antibody (clone 4F9) | 50 μl | Monoclonal Antibodies |
|
$495.00 | Add Ask | ||
| 2 | Leading Biology | AMM04683G | GALT Antibody (clone 4C11) | 50 μg | Monoclonal Antibodies |
|
$545.00 | Add Ask | ||
| 3 | Leading Biology | AMM01402G | Vimentin (Mesenchymal Cell Marker) Antibody - With BSA and Azide | 50 ug | Monoclonal Antibodies |
|
$395.00 | Add Ask | ||
| 4 | Leading Biology | APR08280G | LTA4H / LTA4 Antibody (clone 9G8) | 50 μl | Monoclonal Antibodies |
|
$495.00 | Add Ask | ||
| 5 | Leading Biology | AMM00172G | CD1a / HTA1 (Mature Langerhans Cells Marker) Antibody - With BSA and Azide | 50 ug | Monoclonal Antibodies |
|
$395.00 | Add Ask | ||
| 6 | Leading Biology | AMM05750G | CEBPA Antibody | 100 μl | Monoclonal Antibodies |
|
$545.00 | Add Ask |
 Leading Biology Inc.
2600 Hilltop DR, Building G, B Suite C138
Richmond, CA, 94806
Tel: 1-661-524(LBI)-0262
Email: info@leadingbiology.com
Leading Biology Inc.
2600 Hilltop DR, Building G, B Suite C138
Richmond, CA, 94806
Tel: 1-661-524(LBI)-0262
Email: info@leadingbiology.com
Complete this form and click send to ask us a question, request a quote or simply say hello.

You have 0 item in your cart

You have 0 item in your inquiry list
